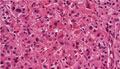

- 13.Endocrine
- ★(13)Adrenocortical adenoma (Cushing syndrome)
Macroscopic findings. Cut surface of the adrenal tumor demonstrates a mixture of yellowish and brownish components. Dotted line indicates the adrenal gland including adenoma.
Click the image to see the enlarged image.